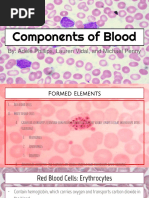

Blood Cell Types and Functions Explained
Uploaded by
Heather Marie MathisBlood Cell Types and Functions Explained
Uploaded by
Heather Marie MathisBlood Components Cell Type Erythrocytes Leukocytes Granulocytes Neutrophils Eosinophils Basophils Agranulocytes Lymphocytes B Cells T Cells NK Cells
Monocytes Diameter 7.8 microns 12-15 microns 12-15 microns 12-15 microns 12-15 microns Small: 6-8 microns (97%) Large: Up to 18 microns (3%) Percentage 45% < 1% 35-71% 1-3% < 1% 25-33% Least of lymphocytes 15-20 microns Platelets (Thrombocyte) Megakaryocyte 2-4 microns 35-160 microns 3-7% < 1% 10 days 1.5 - 3.0 x 106 Long Life Span 120 days 1-4 days Bloodstream - hours Tissues - 4 days Cells Per Liter 4.2 - 5.9 x 106 4.3 - 10.8 x 103
Blood Components Cell Type Erythrocytes Description Picture
Leukocytes Granulocytes Neutrophils
Eosinophils
Basophils
1. Biconcave disc - high surface/volume ratio 2. Interaction of membrane proteins with cytoskeleton holds shape. Is deformable but the normal RBC always returns to the biconcave disc shape. RBCs passing through capillaries whose 7.8 microns average diameter is 5.5 microns drag along the endothelial lining as bullet shaped missiles rebounding to the biconcave disc upon entering the post-capillary venule. 3. Integral membrane protein forms an ANION TRANSPORTER provides way for HCO3- to cross the plasma membrane in exchange for Cl- facilitating the release of CO2 in the lung 4. No organelles; no nucleus; cytoplasm consists of the cytoskeleton, and Hgb which binds O2. 1. Specific Granules (smaller): lysozyme and other proteases specific to that cell (salmon color) 2. Non-Specific/Azurophilic Granules (larger): lysosomes with elastase and myeloperoxidase (blue color) 12-15 microns Functions: (First Responder) 1. Bacterial killing via free radicals, lactoferrin Bands - young; band nuclei Segs - old; segmented nuclei 2. Phagocytosis of bacteria, then destruction via acid hydrolases found in lysosomes Neutrophils are formed in the bone marrow 3. Diapedesis via p-selectins, ICAMs & beta integrins The older it gets, the more lobes Lactoferrin - neutrophils secrete this which binds tightly to iron. Fe is essential to support the Smaller cytoplasmic granules growth of pathogenic bacteria. Use the rule of filament Specific Granules are large, bilobed, and acidophilic composed of : 1. Internum - a crystalline core contains MBP & ECP 2. Externum - contains phosphatase, lipase, peroxidase, RNAase 12-15 microns ECP = eosinophil cationic protein MBP = major basic protein Always have a nucleus with 2 lobes Functions: Large eosinophilic (acidophilic) granules 1. Anti-parasites - MBP and ECP by binding and disrupting parasite membrane Bag of pink marbles 2. Role in allergies - MBP destroys antigen-antibody complexes 3. MBP basophil/mast cell release of histamine 4. Adhesion & migration - cytokines adhesion molecules Specific Granules are large & basophilic containing: 1. Eosinophilic chemotactic factor 2. Heparin, Histamine and Peroxidase 12-15 microns Functions: Large granules; resemble mast cell granules 1. Back up mast cells by secreting histamine & heparin in anti-parasitic immune reactions. Very rare 2. Play key pathogenic roles in allergic reactions. Nucleus is often hidden by basophilic granules 3. During inflammation, secrete leukotrienes causing slow contraction of smooth muscle 4. Migrate to connective tissue via adhesion molecules
Agranulocytes Lymphocytes
No obvious granules with exception of Natural Killer Cell which is large and granular. Functions: 1. Attack foreign cells & microorganisms via immune responses 2. Attack foreign materials/cells via perforin 3. Instruct other cells - come, stay, be quiet, be active, proliferate via cytokines and cell surface 4. Proliferates itself
B Cells T Cells NK Cells Monocytes
Mature in bone marrow and migrate to lymph nodes. Least % Originate in bone marrow but become differentiated in thymus. 75% No obvious granules present. Functions: 1. Circulate in blood for 14 days then migrate into tissues to differentiate into tissue-specific macrophages; phagocytosis of leftovers of damaged tissues; assistance of lysosomal enzymes is essential 2. Coordination of defense and repair via cytokines 3. Antigen presentation to lymphocytes Many cells are derived from monocyte line but differentiations into these types of cells does not complete until the monocyte has left the circulating blood. Bone: Osteoclast; Skin: Langerhans cells; Brain: Microglia; Liver: Kupffer cells; Lung: Alveolar macrophages - Pieces of a megakaryocyte - Basophilic Center (Granulomere) - granules, dense core granules, lysosomes & peroxisomes - Eosinophilic Perimeter (Hyalomere) - peripheral microtubules & microfilaments that maintains shape and movements Functions: 1. Plug small leaks 2. Provide homeostasis in concert with clotting cascade. - Enormous and scattered about in bone marrow - Undergoes karyokinesis but not cytokinesis to become multinucleated - Cytoplasmic maturation with increased dense core granules, -granules, and formation of demarcation membrane system - Platelets bud from cytoplasm (thryombocytopoiesis) & are released into circulation via process sticking through sinusoid wall into the lumen.
Small: 6-8 microns (97%) Large: Up to 18 microns (3%) 75% T Cells Reside in lymph nodes No segmentation of the nucleus Sparse amount in cytoplasm No specific granules
15-20 microns No obvious granules present Dented nucleus, less basophilic than lymphocyte Chromatin is coarse linear clumps Cytoplasm is basophilic; contains vacuoles and very small Azurophilic lysosomes
Platelets (Thrombocyte)
2-4 microns Basophilic Center (Granulomere) Eosinophilic Perimeter (Hyalomere)
Megakaryocyte
35-160 microns